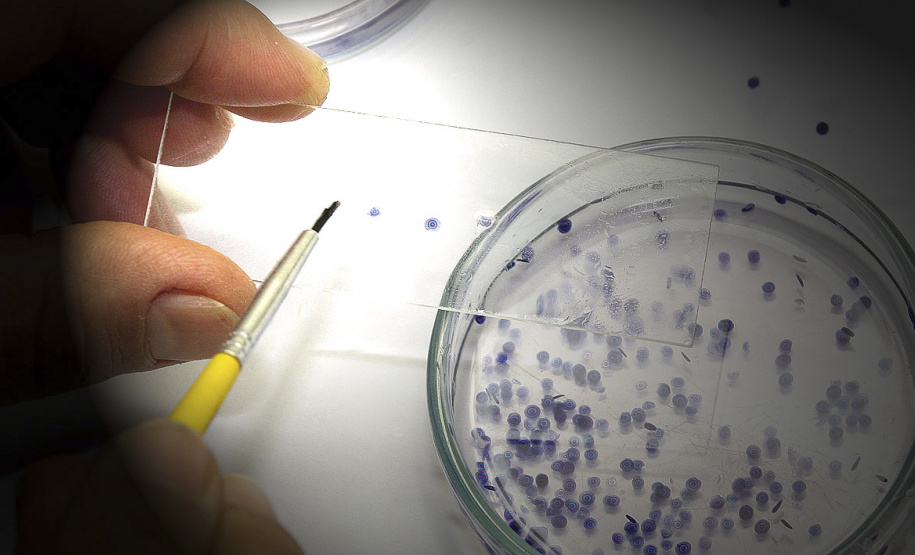
Pesquisa é ponto forte na UEM, inserindo-a como uma das melhores universidades da América Latina .Foto: UEM

A Universidade Estadual de Maringá (UEM) completa neste sábado,0 6 de novembro, 52 anos de atividades. Posicionada como uma das melhores instituições de ensino superior da América Latina e sexta melhor estadual do Brasil, a UEM é uma referência em formação de pessoas, produção de conhecimentos e prestação de serviços, notadamente promotora do desenvolvimento paranaense, tanto no âmbito socioeconomico quanto nas áreas da saúde, agronegócio, cultura, ciência, tecnologia, inovação.
Universidade pública, gratuita, de qualidade e inclusiva, a UEM tem forte tradição em Ensino, Pesquisa e Extensão, além de manter parcerias público-privadas e convênios com universidades estrangeiras em todos os continentes. É prestadora dos mais variados serviços à população, bem como tem sua comunidade científica, competente e reconhecida nacional e internacionalmente, envolvida com pesquisas e inovação.
Com cerca de 70 cursos de graduação presenciais e a distância, em todas as áreas do conhecimento, a UEM já formou humana e intelectualmente 77.673 profissionais para o Brasil e para o mundo. Além disso, a instituição forma especialistas, mestres em 56 cursos e doutores em 29 cursos.
- Prazo para inscrição ao PAS e Vestibular 2021 da UEM vai até segunda-feira
- UEM lança série de vídeos para apresentar pesquisas de programas de pós-graduação
Atualmente são em torno de 20 mil estudantes em graduação e pós-graduação, segundo a Pró-Reitoria de Planejamento e Desenvolvimento Institucional (PLD), mais aproximadamente 1,2 mil matriculados no Centro Municipal de Educação Infantil (CMEI) integrado à UEM e no Colégio de Aplicação Pedagógica (CAP), além de mais de 3,6 mil servidores públicos.
INSTALAÇÃO - Adriano José Valente, prefeito maringaense de 1969 a 1972, desapropriou um terreno com quase 80 alqueires para instalar o Câmpus Universitário na Zona 7 de Maringá, onde ainda hoje fica o câmpus sede. Uma comissão fez estudos de viabilidade econômica de criação da UEM e o resultado foi apresentado ao então governador do Paraná, Paulo Pimentel.
O contexto histórico era de grande efervescência, já que pouco mais de três meses após o homem pisar na Lua, a Lei Estadual 6.034/69 do Paraná foi promulgada em 6 de novembro de 1969, nomeando José Carlos Cal Garcia como primeiro reitor da UEM e Ayrton Pinheiro, vice. Junto à UEM, foram criadas as universidades estaduais de Londrina (UEL) e Ponta Grossa (UEPG).
Julio César Damasceno, reitor da UEM, faz um retrospecto histórico e conta o que a UEM representa.
PRIMEIRA DIPLOMADA - Aos 82 anos de idade, a aposentada Alzira Miszga fica surpresa ao descobrir que é a primeira diplomada da UEM com registro feito pela própria universidade, datado de 12 de janeiro de 1977. Moradora de Curitiba, formou-se em Letras Franco-Portuguesas e chegou a trabalhar na UEM, na Diretoria de Assuntos Acadêmicos (DAA) e na Pró-Reitoria de Extensão e Cultura (PEC). “Os meus professores foram maravilhosos e a UEM era avançada tecnologicamente, mesmo sendo de uma cidade do Interior”, relembra.
INFRAESTRUTURA - Conforme a PLD, a UEM possui 5.303.405,46 metros quadrados de área física, que abriga instalações como blocos didáticos (salas de aula e laboratórios), blocos administrativos, bibliotecas, restaurante e refeitórios, Universidade Aberta à Terceira Idade (Unati), Hospital Veterinário Universitário, Complexo de Saúde, Complexo de Centrais de Apoio à Pesquisa (Comcap), Escola de Música, anfiteatros e auditórios, museus, Editora (Eduem), institutos de idiomas, estação climatológica, Complexo Esportivo, entre outros.
O Complexo de Saúde é formado pelo Hospital Universitário Regional de Maringá (HUM), o Hemocentro, a Clínica Odontológica, a Unidade de Psicologia Aplicada (UPA), o Laboratório de Ensino e Prática em Análises Clínicas (Lepac) e a Farmácia Ensino, que realizam de graça diversos atendimentos à população do norte paranaense.
CIDADES - A UEM tem sete câmpus no Paraná, em Cianorte, Cidade Gaúcha, Diamante do Norte, Goioerê, Ivaiporã, Maringá (sede) e Umuarama. Também há polos de apoio presencial do Núcleo de Educação a Distância (Nead) no Paraná, a Fazenda Experimental de Iguatemi (FEI) e a base avançada de pesquisas do Núcleo de Pesquisas em Limnologia, Ictiologia e Aquicultura (Nupélia) em Porto Rico.
VÁRIOS ANIVERSÁRIOS - Pode-se afirmar que a UEM tem várias datas de aniversário. O pontapé inicial foi em 28 de agosto de 1959, com o surgimento da Faculdade de Ciências Econômicas. Outros marcos são 21 de dezembro de 1965 (Faculdade de Direito), 24 de dezembro de 1966 (Faculdade de Filosofia, Ciências e Letras), 5 de novembro de 1969 (Instituto de Ciências Exatas e Tecnológicas/Icet), 28 de janeiro de 1970 (fundação de direito público da UEM era criada pelo Decreto Estadual 18.109/70) e 11 de maio de 1976 (reconhecimento da universidade por meio do Decreto Federal 77.583/76; veja como foi este momento histórico.